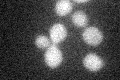
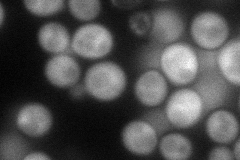
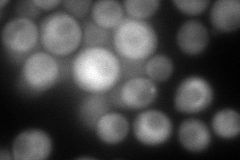
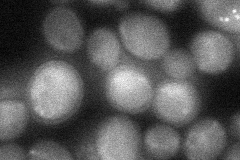
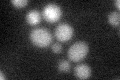

View description
Component of autophagosomes and Cvt vesicles; undergoes conjugation to phosphatidylethanolamine (PE); Atg8p-PE is anchored to membranes, is involved in phagophore expansion, and may mediate membrane fusion during autophagosome formation
Localization:
Intensity:
Fold change:
Significance:
-
C’ GFP library in SD
below threshold16.62 -
N' NOP1pr-GFP in SD
cytosol,punctate75.9418 -
N' TEF2pr-mCherry in SD
cytosol,punctate189.935 -
N' NATIVEpr-GFP in SD

punctate27.5728 -
N' TEF2pr-VC and Cyto-VN in SD
cytosol,punctate38.4164 -
C’ GFP library in SD+DTT
cytosol15.420.92No -
C’ GFP library in SD+H2O2

cytosol15.280.91No -
C’ GFP library in Starvation Media

cytosol15.240.91No -
C’ GFP library on the background of Pup2-DaMP

below threshold -
C’ GFP library on the background of CCT mutant

below thresholdN/AN/ANo
